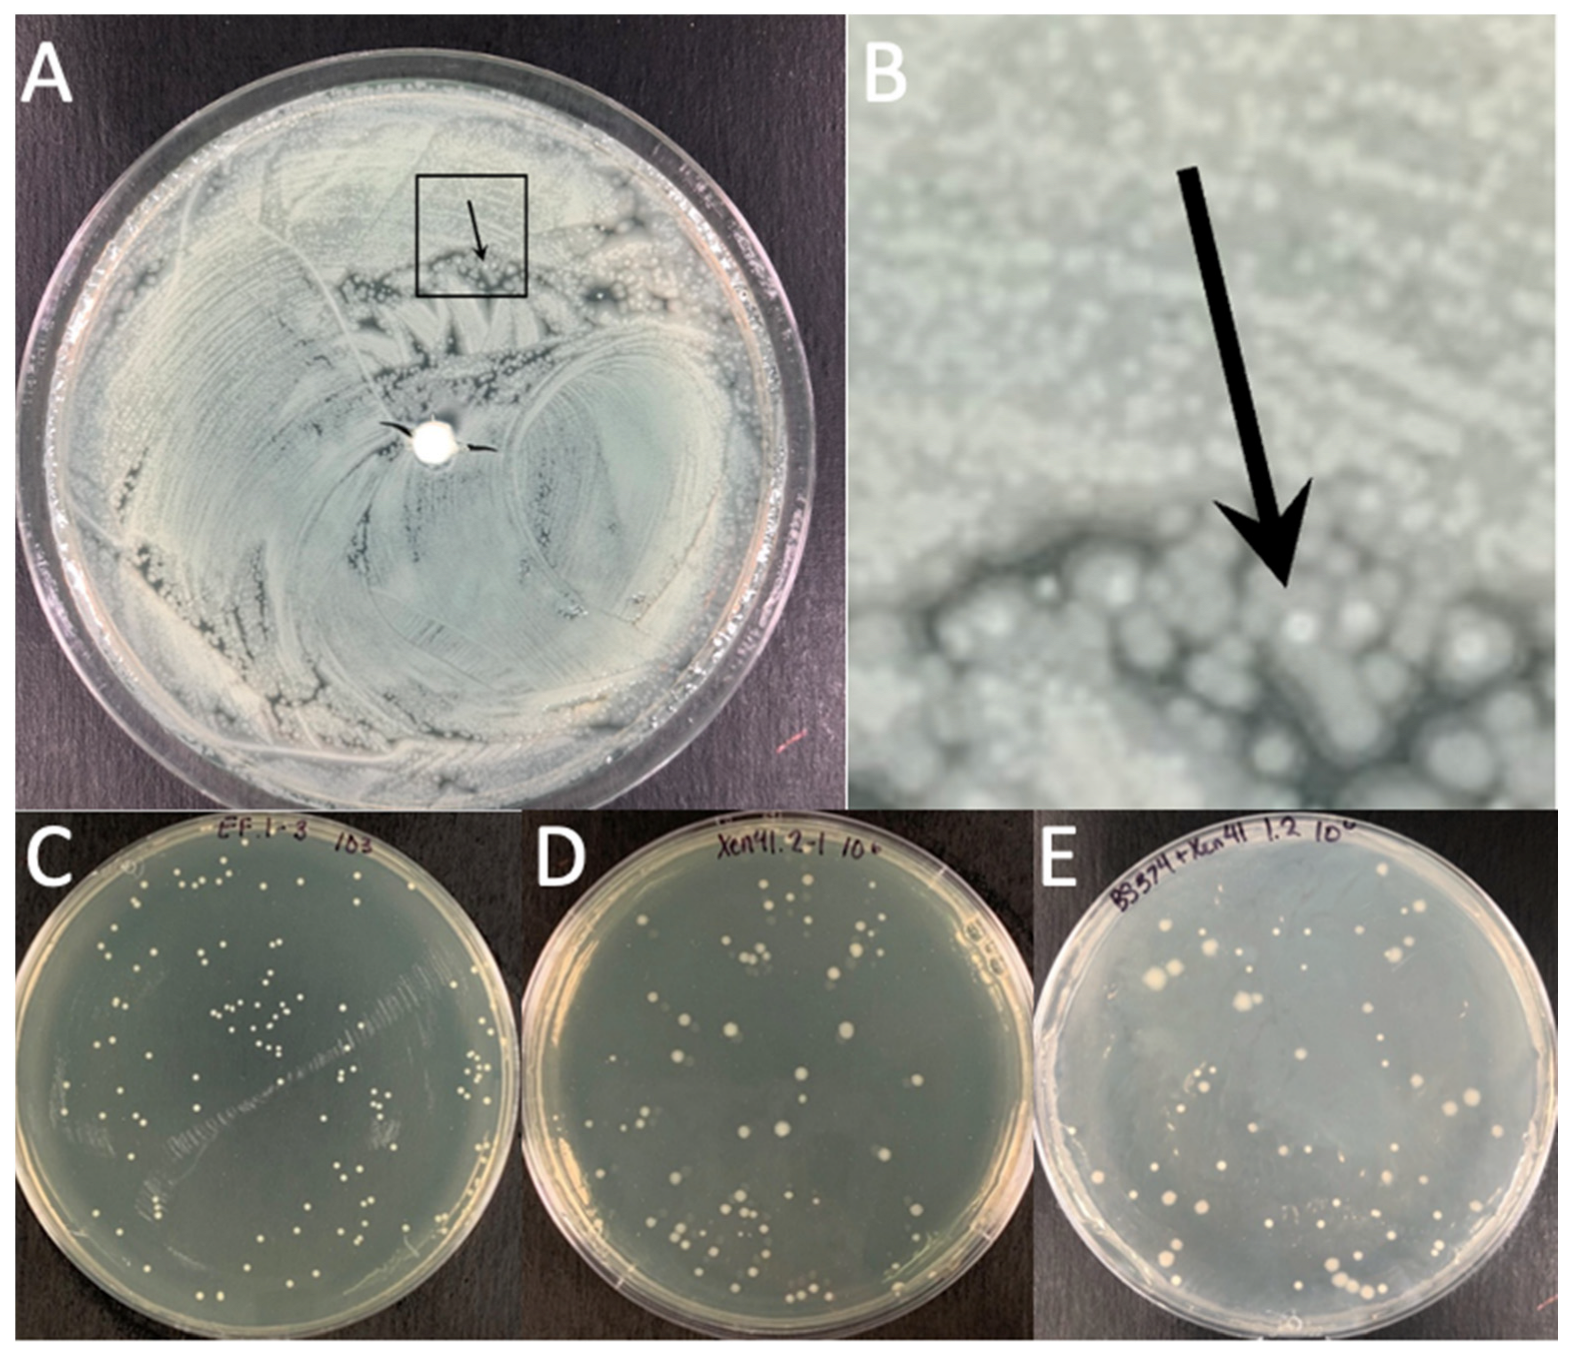
Microorganisms 11 02296 g004

Killing of a Multispecies Biofilm Using Gram-Negative and Gram-Positive Targeted Antibiotic Released from High Purity Calcium Sulfate Beads
Abstract
:1. Introduction
2. Materials and Methods
2.1. Bacteria
2.2. Biofilm Development and Preliminary Screening for Compatible Gram Positive and Negative Pairs
2.3. Scanning Electron Microscopy (SEM)
2.4. Minimum Inhibition Concentration (MIC) Using E-Test Strips
2.5. Preparation of High Purity Antibiotic Loaded Calcium Sulfate Beads
2.6. Antibiotic Challenge
2.7. Agar Plate Model
2.8. Statistics
3. Results
3.1. Preliminary Screen for a Compatible Pair Multispecies Biofilm
3.2. Antibiotic Challenge of EF + PA Biofilms Grown on 316L-SS from HP-ALCSB as Mono and Dual Treatments
3.3. Antibiotic Challenge on an EF + PA Biofilm Grown on Agar from HP-ALCSB as Mono and Dual Therapy
4. Discussion
5. Conclusions
- (1)
- We were able to establish a Gram negative and Gram positive dual species biofilm of P. aeruginosa and E. faecalis on 316L stainless steel surfaces in approximately the same numerical proportions.
- (2)
- A dual combination of vancomycin and tobramycin released from high purity absorbable bone filler beads significantly reduced more biofilm bacteria than either antibiotic used alone.
- (3)
- Local release of multiple antibiotics resulting, in high concentrations and multiple mechanisms of action, may be more effective in treating PJIs involving multi-species biofilms with different antibiotic susceptibilities may be treated more effectively than from a single antibiotic alone.
Supplementary Materials
Author Contributions
Funding
Institutional Review Board Statement
Informed Consent Statement
Data Availability Statement
Conflicts of Interest
References
- Premkumar, A.; Kolin, D.A.; Farley, K.X.; Wilson, J.M.; McLawhorn, A.S.; Cross, M.B.; Sculco, P.K. Projected Economic Burden of Periprosthetic Joint Infection of the Hip and Knee in the United States. J. Arthroplast. 2021, 36, 1484–1489.e3. [Google Scholar] [CrossRef] [PubMed]
- Bozzo, A.; Ekhtiari, S.; Madden, K.; Bhandari, M.; Ghert, M.; Khanna, V.; Pond, G.R.; Winemaker, M.J.; Wood, T.; Adili, A. Incidence and Predictors of Prosthetic Joint Infection Following Primary Total Knee Arthroplasty: A 15-Year Population-Based Cohort Study. J. Arthroplast. 2021, 37, 367–372.e1. [Google Scholar] [CrossRef] [PubMed]
- Malchau, K.S.; Tillander, J.; Zaborowska, M.; Hoffman, M.; Lasa, I.; Thomsen, P.; Malchau, H.; Rolfson, O.; Trobos, M. Biofilm properties in relation to treatment outcome in patients with first-time periprosthetic hip or knee joint infection. J. Orthop. Transl. 2021, 30, 31–40. [Google Scholar] [CrossRef]
- Osmon, D.R.; Berbari, E.F.; Berendt, A.R.; Lew, D.; Zimmerli, W.; Steckelberg, J.M.; Rao, N.; Hanssen, A.; Wilson, W.R. Executive Summary: Diagnosis and Management of Prosthetic Joint Infection: Clinical Practice Guidelines by the Infectious Diseases Society of Americaa. Clin. Infect. Dis. 2013, 56, 1–10. [Google Scholar] [CrossRef]
- Flurin, L.; Greenwood-Quaintance, K.E.; Patel, R. Microbiology of polymicrobial prosthetic joint infection. Diagn. Microbiol. Infect. Dis. 2019, 94, 255–259. [Google Scholar] [CrossRef]
- Gbejuade, H.O.; Lovering, A.M.; Webb, J.C. The role of microbial biofilms in prosthetic joint infections: A review. Acta Orthop. 2015, 86, 147–158. [Google Scholar] [CrossRef] [PubMed]
- Burgo, F.J.; Mengelle, D.E.; Abraham, A.; Kremer, G.; Autorino, C.M. Periprosthetic fungal infection of a hip caused by Trichosporon inkin. Arthroplast. Today 2018, 4, 24–26. [Google Scholar] [CrossRef]
- Meyssonnier, V.; Zeller, V.; Malbos, S.; Heym, B.; Lhotellier, L.; Desplaces, N.; Marmor, S.; Ziza, J.-M. Prosthetic joint infections due to Mycobacterium tuberculosis: A retrospective study. Jt. Bone Spine 2019, 86, 239–243. [Google Scholar] [CrossRef]
- Johansson, L.; Hailer, N.P.; Rahme, H. High incidence of periprosthetic joint infection with propionibacterium acnes after the use of a stemless shoulder prosthesis with metaphyseal screw fixation—A retrospective cohort study of 241 patients propionibacter infections after eclipse TSA. BMC Musculoskelet. Disord. 2017, 18, 203. [Google Scholar] [CrossRef]
- Makovcova, J.; Babak, V.; Kulich, P.; Masek, J.; Slany, M.; Cincarova, L. Dynamics of mono- and dual-species biofilm formation and interactions between Staphylococcus aureus and Gram-negative bacteria. Microb. Biotechnol. 2017, 10, 819–832. [Google Scholar] [CrossRef]
- Ciofu, O.; Rojo-Molinero, E.; Macià, M.D.; Oliver, A. Antibiotic treatment of biofilm infections. Apmis 2017, 125, 304–319. [Google Scholar] [CrossRef]
- Stoodley, P.; Sauer, K.; Davies, D.G.; Costerton, J.W. Biofilms as complex differentiated communities. Annu. Rev. Microbiol. 2002, 56, 187–209. [Google Scholar] [CrossRef]
- O’Toole, G.O.; Kaplan, H.B.; Kolter, R. Biofilm formation as microbial development. Ann. Rev. Microbiol. 2000, 54, 49–79. [Google Scholar] [CrossRef]
- Messiaen, A.S.; Nelis, H.; Coenye, T. Investigating the role of matrix components in protection of Burkholderia cepacia complex biofilms against tobramycin. J. Cyst. Fibros 2014, 13, 56–62. [Google Scholar] [CrossRef]
- Post, V.; Wahl, P.; Richards, R.G.; Moriarty, T.F. Vancomycin displays time-dependent eradication of mature Staphylococcus aureus biofilms. J. Orthop. Res. 2017, 35, 381–388. [Google Scholar] [CrossRef]
- Tavernier, S.; Crabbé, A.; Hacioglu, M.; Stuer, L.; Henry, S.; Rigole, P.; Dhondt, I.; Coenye, T. Community Composition Determines Activity of Antibiotics against Multispecies Biofilms. Antimicrob. Agents Chemother. 2017, 61, e00302-17. [Google Scholar] [CrossRef]
- Li, T.; Fu, L.; Wang, J.; Shi, Z. High dose of vancomycin plus gentamicin incorporated acrylic bone cement decreased the elution of vancomycin. Infect. Drug Resist. 2019, 12, 2191–2199. [Google Scholar] [CrossRef] [PubMed]
- McConoughey, S.J.; Howlin, R.P.; Wiseman, J.; Stoodley, P.; Calhoun, J.H. Comparing PMMA and calcium sulfate as carriers for the local delivery of antibiotics to infected surgical sites. J. Biomed. Mater. Res. 2014, 103, 870–877. [Google Scholar] [CrossRef] [PubMed]
- Moley, J.P.; McGrath, M.S.; Granger, J.F.; Stoodley, P.; Dusane, D.H. Reduction in Pseudomonas aeruginosa and Staphylococcus aureus biofilms from implant materials in a diffusion dominated environment. J. Orthop. Res. 2018, 36, 3081–3085. [Google Scholar] [CrossRef] [PubMed]
- Kathju, S.; Nistico, L.; Melton-Kreft, R.; Lasko, L.A.; Stoodley, P. Direct Demonstration of Bacterial Biofilms on Prosthetic Mesh after Ventral Herniorrhaphy. Surg. Infect. 2015, 16, 45–53. [Google Scholar] [CrossRef]
- Stoodley, P.; Sidhu, S.; Nistico, L.; Mather, M.; Boucek, A.; Hall-Stoodley, L.; Kathju, S. Kinetics and morphology of polymicrobial biofilm formation on polypropylene mesh. FEMS Immunol. Med. Microbiol. 2012, 65, 283–290. [Google Scholar] [CrossRef] [PubMed]
- Ratner, B.D.; Hoffman, A.S.; Schoen, F.J.; Lemons, J.E. Biomaterials science: An introduction to materials in medicine. MRS Bull 2006, 31, 58–60. [Google Scholar]
- Goeres, D.M.; Walker, D.K.; Buckingham-Meyer, K.; Lorenz, L.; Summers, J.; Fritz, B.; Goveia, D.; Dickerman, G.; Schultz, J.; Parker, A.E. Development, standardization, and validation of a biofilm efficacy test: The single tube method. J. Microbiol. Methods 2019, 165, 105694. [Google Scholar] [CrossRef] [PubMed]
- Anagnostakos, K. What do we (not) know about antibiotic-loaded hip spacers? Orthopedics 2014, 37, 297–298. [Google Scholar] [CrossRef] [PubMed]
- Stimulan® Rapid Cure: Instructions for Use. 2019. Available online: https://www.biocomposites.com/our-products/stimulan/ (accessed on 1 September 2022).
- Dusane, D.H.; Brooks, J.R.; Sindeldecker, D.; Peters, C.W.; Li, A.; Farrar, N.R.; Diamond, S.M.; Knecht, C.S.; Plaut, R.D.; Delury, C.; et al. Complete killing of agar lawn biofilms by systematic spacing of antibiotic-loaded calcium sulfate beads. Materials 2019, 12, 4052. [Google Scholar] [CrossRef]
- Dusane, D.H.; Diamond, S.M.; Knecht, C.S.; Farrar, N.R.; Peters, C.W.; Howlin, R.P.; Swearingen, M.C.; Calhoun, J.H.; Plaut, R.D.; Nocera, T.M.; et al. Effects of loading concentration, blood and synovial fluid on antibiotic release and anti-biofilm activity of bone cement beads. J. Control. Release 2017, 248, 24–32. [Google Scholar] [CrossRef]
- Dusane, D.H.; Lochab, V.; Jones, T.; Peters, C.W.; Sindeldecker, D.; Das, A.; Roy, S.; Sen, C.K.; Subramaniam, V.V.; Wozniak, D.J.; et al. Electroceutical Treatment of Pseudomonas aeruginosa Biofilms. Sci. Rep. 2019, 9, 2008. [Google Scholar] [CrossRef]
- Fernandes, A.; Dias, M. The microbiological profiles of infected prosthetic implants with an emphasis on the organisms which form biofilms. J. Clin. Diagn. Res. 2013, 7, 219–223. [Google Scholar] [CrossRef]
- Dowd, S.E.; Wolcott, R.D.; Sun, Y.; McKeehan, T.; Smith, E.; Rhoads, D. Polymicrobial nature of chronic diabetic foot ulcer biofilm infections determined using bacterial tag encoded FLX amplicon pyrosequencing (bTEFAP). PLoS ONE 2008, 3, e3326. [Google Scholar] [CrossRef]
- Sindeldecker, D.; Moore, K.; Li, A.; Wozniak, D.J.; Anderson, M.; Dusane, D.H.; Stoodley, P. Novel Aminoglycoside-Tolerant Phoenix Colony Variants of Pseudomonas aeruginosa. Antimicrob. Agents Chemother. 2020, 64, e00623-20. [Google Scholar] [CrossRef]
- Marculescu, C.E.; Cantey, J.R. Polymicrobial prosthetic joint infections: Risk factors and outcome. Clin. Orthop. Relat. Res. 2008, 466, 1397–1404. [Google Scholar] [CrossRef] [PubMed]
- Kavolus, J.J.; Cunningham, D.J.; Rao, S.R.; Wellman, S.S.; Seyler, T.M. Polymicrobial Infections in Hip Arthroplasty: Lower Treatment Success Rate, Increased Surgery, and Longer Hospitalization. J. Arthroplast. 2019, 34, 710–716.e3. [Google Scholar] [CrossRef] [PubMed]
- Chan, D.C.K.; Dykema, K.; Fatima, M.; Harvey, H.; Quaderi, I.; Burrows, L.L. Nutrient Limitation Sensitizes Pseudomonas aeruginosa to Vancomycin. ACS Infect. Dis. 2023, 9, 1408–1423. [Google Scholar] [CrossRef] [PubMed]
- Tavernier, S.; Sass, A.; De Bruyne, M.; Baeke, F.; De Rycke, R.; Crabbé, A.; Vandecandelaere, I.; Van Nieuwerburgh, F.; Coenye, T. Decreased susceptibility of Streptococcus anginosus to vancomycin in a multispecies biofilm is due to increased thickness of the cell wall. J. Antimicrob. Chemother. 2018, 73, 2323–2330. [Google Scholar] [CrossRef] [PubMed]
- Beaudoin, T.; Yau, Y.C.W.; Stapleton, P.J.; Gong, Y.; Wang, P.W.; Guttman, D.S.; Waters, V. Staphylococcus aureus interaction with Pseudomonas aeruginosa biofilm enhances tobramycin resistance. Npj Biofilms Microbiomes 2017, 3, 25. [Google Scholar] [CrossRef]
- Keehoon Lee Donggeun Kim Sang Sun Yoona, K.-M.L. Molecular Determinants of the Thickened Matrix in a Dual-Species. Appl. Environ. Microbiol. 2017, 83, e01182-17. [Google Scholar]
- Del Mar Cendra, M.; Torrents, E. Pseudomonas aeruginosa biofilms and their partners in crime. Biotechnol. Adv. 2021, 49, 107734. [Google Scholar] [CrossRef]
- Day, C.A.; Marceau-Day, M.L.; Day, D.F. Increased susceptibility of Pseudomonas aeruginosa to ciprofloxacin in the presence of vancomycin. Antimicrob. Agents Chemother. 1993, 37, 2506–2508. [Google Scholar] [CrossRef]
- Sindeldecker, D.; Dunn, M.; Zimmer, A.; Anderson, M.; Alfonzo, J.; Stoodley, P. Genomic and transcriptomic profiling of phoenix colonies. Sci. Rep. 2022, 12, 13726. [Google Scholar] [CrossRef]
- Berberich, C.; Sanz-Ruiz, P. Risk assessment of antibiotic resistance development by antibiotic-loaded bone cements: Is it a clinical concern? EFORT Open Rev. 2019, 4, 576–584. [Google Scholar] [CrossRef]
- Fletcher, J.; Porter, R.; Boulton, Z.; Brown, L.; Knight, B.; Romanczuk, L.; Aiken, S.; Delury, C.; Michell, S. In vitro efficacy of antibiotic loaded calcium sulfate beads (Stimulan Rapid Cure) against polymicrobial communities and individual bacterial strains derived from diabetic foot infections. J. Med. Microbiol. 2022, 71, 1–11. [Google Scholar] [CrossRef] [PubMed]
- González Della Valle, A.; Bostrom, M.; Brause, B.; Harney, C.; Salvati, E.A. Effective bactericidal activity of tobramycin and vancomycin eluted from acrylic bone cement. Acta Orthop. Scand. 2001, 72, 237–240. [Google Scholar] [CrossRef] [PubMed]

| VAN (EF-BS374) | VAN (PA-XEN41) | TOB (EF-BS374) | TOB (PA-XEN41) | VAN + TOB(EF-BS374) | VAN + TOB (PA-XEN41) | VAN + TOB–EF-BS374 Alone | VAN + TOB–PA-XEN41 Alone | |
|---|---|---|---|---|---|---|---|---|
| Zone of Killing (mm) | 100 ± 0 | 0 ± 0 | 56.3 ± 3.44 | 51.8 ± 8.10 | 56.6 ± 2.83 | 56.1 ± 5.88 | 72.8 ± 3.71 | 50.2 ± 1.84 |
| Zone of Variants (mm) | 0 ± 0 | 0 ± 0 | 0 ± 0 | 48.2 ± 8.1 | 0 ± 0 | 43.9 ± 5.88 | 0 ± 0 | 49.8 ± 1.84 |
| Zone of Biofilm (mm) | 0 ± 0 | 100 ± 0 | 43.7 ± 3.44 | 0 | 43.5 ± 2.83 | 0 | 27.2 ± 3.71 | 0 ± 0 |
| # of Variants (count) | 0 ± 0 | 0 ± 0 | 0 ± 0 | 113 ± 10.07 | 0 ± 0 | 60 ± 4 | 0 ± 0 | 175 ± 9.64 |
Disclaimer/Publisher’s Note: The statements, opinions and data contained in all publications are solely those of the individual author(s) and contributor(s) and not of MDPI and/or the editor(s). MDPI and/or the editor(s) disclaim responsibility for any injury to people or property resulting from any ideas, methods, instructions or products referred to in the content. |
© 2023 by the authors. Licensee MDPI, Basel, Switzerland. This article is an open access article distributed under the terms and conditions of the Creative Commons Attribution (CC BY) license (https://creativecommons.org/licenses/by/4.0/).
Share and Cite
Moore, K.; Li, A.; Gupta, N.; Gupta, T.T.; Delury, C.; Aiken, S.S.; Laycock, P.A.; Stoodley, P. Killing of a Multispecies Biofilm Using Gram-Negative and Gram-Positive Targeted Antibiotic Released from High Purity Calcium Sulfate Beads. Microorganisms 2023, 11, 2296. https://doi.org/10.3390/microorganisms11092296
Moore K, Li A, Gupta N, Gupta TT, Delury C, Aiken SS, Laycock PA, Stoodley P. Killing of a Multispecies Biofilm Using Gram-Negative and Gram-Positive Targeted Antibiotic Released from High Purity Calcium Sulfate Beads. Microorganisms. 2023; 11(9):2296. https://doi.org/10.3390/microorganisms11092296
Chicago/Turabian StyleMoore, Kelly, Anthony Li, Niraj Gupta, Tripti Thapa Gupta, Craig Delury, Sean S. Aiken, Phillip A. Laycock, and Paul Stoodley. 2023. "Killing of a Multispecies Biofilm Using Gram-Negative and Gram-Positive Targeted Antibiotic Released from High Purity Calcium Sulfate Beads" Microorganisms 11, no. 9: 2296. https://doi.org/10.3390/microorganisms11092296
APA StyleMoore, K., Li, A., Gupta, N., Gupta, T. T., Delury, C., Aiken, S. S., Laycock, P. A., & Stoodley, P. (2023). Killing of a Multispecies Biofilm Using Gram-Negative and Gram-Positive Targeted Antibiotic Released from High Purity Calcium Sulfate Beads. Microorganisms, 11(9), 2296. https://doi.org/10.3390/microorganisms11092296

